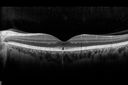
outeretinalhole_cach1_012915_17.jpg

|
|

Proliferative Diabetic Retinopathy - Moderate - mild NVD with NVE 882 viewsVenous beading, vascular loops and NVE are visible on photos
|
|

Retinitis Pigmentosa Sine Pigmento 882 views
|
|

Occult Maculopathy - Thin Fovea on OCT and Normal Color VA, Photos, FA VA 20/80 OU881 views45-year-old man his mother and his maternal grandmother each had vision loss at a relatively young age. Retina OS normal
|
|

Sclerochoroidal Calcification - 72 Year Old Woman 881 views72-year-old woman who has spots on her lungs, which she has been told are scar tissue 20/30 OU
|
|

Choroidal Neovascular Membrane - Optic Disc Drusen - Hemorrhage (Coumadin) 881 views82-year-old man with decreased vision in the left eye over about the last six to 12 months. He is also on Coumadin. OD 20/20, OS 20/80
|
|

Silicone Oil in Anterior Chamber and Band Keratopathy 8 Years Post Complex Retinal Detachment Repair881 views81-year-old man had complex retinal detachment repairs in both eyes with silicone oil 8 years ago. The left eye has an oil fill. He had a retinotomy very near to the macula and he has had silicone oil in the eye for a few years. His eye is comfortable and the vision is stable. OD is 20/200, OS is light perception
|
|

Chronic Retinal Detachment - Pigment Line - Subretinal Fibrosis881 views60 year old with temporal macula-on chronic retinal detachment. No treatment was done.
|
|

Acute Cytomegalovirus Retinitis881 views45 y/o male presents with newly diagnosed AIDS and retinal infiltrates.
|
|

Retinitis Pigmentosa Sine Pigmento 881 views
|
|

Punctate Inner Choroidopathy - PIC and Choroidal Neovascular Membrane - Right Eye - Color Fundus Photograph880 views34-year-old woman with a change in vision in the right eye about eight days ago. Her vision was hazy and she saw waviness in the vision. She does have a history of aches and pains and she was diagnosed with Sjogren’s and 2 months ago she had some fevers and some sinus drainage and that went on for about two months. She is a moderate myope. OD 20/25, OS 20/20.
|
|

Optic Nerve (Disc) Drusen vs. Disc Edema Vs. AION - Spectral Domain Optical Coherence Tomography Line Scan880 views
|
|

Sturge-Weber Encephalotigeminal Angiomatosis - Facial Hemangioma and Asymptomatic Ipsilateral Diffuse Choroidal Hemangioma879 views61-year-old man with Sturge-Weber syndrome with a hemangioma on the left side of his face.
VISUAL ACUITY: Vision OD is 20/50, PH 20/30; OS 20/80, PH 20/30. IOP: OD 16, OS 19.
|
|

Concentric Annular Macular Dystrophy 4/200 2/200 vision 61 Year Old Macular Crystals879 views61-year-old woman has concentric annular macular dystrophy. She has had vision loss for 10 years who is no longer able to function even with the magnifiers and vision aids that she has. Her brother who is ten years younger than her, is recently diagnosed with the same macular dystrophy and her father and grandfather may have had similar problems in the past.
VISUAL ACUITY: OD 4/200, OS 2/200.
|
|

Central Areolar Choroidal Dystrophy879 viewsVision loss from early 60's. This 78 year old woman has choroidal atrophy centrally.
|
|

Plaquenil (Hydroxycholorquine) Toxicity - Bull's Eye Maculopathy - 73 year old womand 25 Years therapy - 64 inches tall - 110 lbs878 views73-year-old woman has been on Plaquenil for twenty five years. She noticed loss of paracentral vision a few months ago. VISUAL ACUITY: OD 20/70, OS 20/30. Her color vision was 0 out 10 correct in both eyes and she also missed the controls.
|
|

Chronic Retinal Detachment - Pigment Line - Subretinal Fibrosis878 views60 year old with temporal macula-on chronic retinal detachment. No treatment was done.
|
|

Acute Posterior Multifocal Placoid Pigment Epitheliopathy - APMPPE - Indocyanine Green Angiogram878 views 25-year-old man with one and half weeks ago he woke up with night chills. Also around that time his joints started hurting him. He also has headaches, although the headache at this point is not severe. His vision has been changing for about the last week and a half. He sees some spots in his vision and they are blurred spots. They are not in the central vision.
VISUAL ACUITY: OD 20/32, OS 20/32
|
|

Toxocariasis877 views15-year-old one year ago had pink eye then her vision has been abnormal. She recently went for a drivers’ test and failed, OD: 20/80; OS: 20/20.
|
|

69 Year Old Woman Normal Red Free876 views69-year-old woman OD 20/50 - OS 20/30 ATYPICAL PHOTOPSIAS
|
|

Chronic Central Serous Retinopathy treated with Photodynamic Laser and Visudyne875 views48-year-old man has had waxing and waning vision in the left eye for the last year from central serous retinopathy. OD is 20/16, OS is 20/30.
|
|

Acute Posterior Multifocal Placoid Pigment Epitheliopathy - APMPPE - Fundus Photo - Color875 views 25-year-old man with one and half weeks ago he woke up with night chills. Also around that time his joints started hurting him. He also has headaches, although the headache at this point is not severe. His vision has been changing for about the last week and a half. He sees some spots in his vision and they are blurred spots. They are not in the central vision.
VISUAL ACUITY: OD 20/32, OS 20/32
|
|

Hypertensive Retinopathy875 viewsPatient comes in complaining of spots in vision in both eyes. VA was 20/25 - right eye and 20/20- left eye. Fundus exam reveals little hemorrhages with cotton wool spots due to hypertension and anemia.
|
|

69 Year Old Woman Normal Fluorescein Angiogram874 views69-year-old woman OD 20/50 - OS 20/30 ATYPICAL PHOTOPSIAS
|
|

Pigmented Peripheral Retinal Degeneration874 views42-year old male comes in for routine eye exam and to follow up on peripheral retinal degeneration in both eyes. VA is 20/20, right eye and 20/25, left eye. Patient is asymptomatic with no visual complaints.
|
|

Proliferative Diabetic Retinopathy - Moderate - mild NVD with NVE 874 viewsVenous beading, vascular loops and NVE are visible on photos
|
|

Heavy Panretinal Photocoagulation for proliferative diabetic retinopathy (PRP for PDR)874 views78 year old man who had laser for proliferative diabetic retinopathy in 1981. These photos are from 2020. The left eye also had multiple surgeries for diabetic traction retinal detachment. VA OD 20/32, OS HM
|
|

Idiopathic Cystoid Macular Edema - CME - Responded to Subtenons Kenalog - Color Photo Showing Foveal Cysts873 views49-year-old man had a flu two weeks ago the right eye has been throbbing and his vision in the right eye has been foggy. OD 20/80, OS 20/40. IOP: 14 OU.
|
|

873 views
|
|

Diabetic Patient with Macular Edema and Blood Pressure 200/95872 views49-year-old decreasing vision over the last year. OD is 20/80, OS 20/80. blood pressure which was 200/95.
|
|

Retinal Pigment Epithelial Dysgenesis872 views
|
|

Diabetic Retinopathy - Foveal Laser Scar Right Eye872 views74-year-old woman has diabetic retinopathy in both eyes. She has had focal laser in her right eye done elsewhere in the mid 90’s and unfortunately the laser was fairly close to the center and as time progressed she developed foveal atrophy around the scars. She has noticed her vision declining since she was here last a year ago. She does take Travatan in both eyes at night for glaucoma.
VISUAL ACUITY: OD 20/200, OS 20/40.
|
|

TID (Trans Illumination Defect) Christmas Tree Effect872 viewsPatient who is followed up for glaucoma. Retro Illumination reveals the Christmas Tree Effect.
|
|

Optic Nerve Drusen - - Nerve Fiber Layer Scan871 views72-year-old woman has had optic nerve drusen for sometime and has visual field abnormalities. OD 20/32, OS 20/32.
|
|

6mm x 11mm Melanoma871 views76 year old male present with a 6mm x 1mm melanoma. Large melanoma very nasal OS. Asteroid Hyalosis present OS only. VA 20/40 OD 20/40 OS.
|
|
Outer Retinal Holes - Probably Solar Retinopathy (history is negative)871 views
|
|

Best Disease, Vitelliform Macular Dystrophy - 6 year old child870 viewsVISUAL ACUITY: Vision OD is 20/30, OS is 20/100.
|
|

Diabetic and Pseudophakic Cystoid Macular Edema Pretreatment Fundus Photo870 views56-year-old woman has diabetic retinopathy in both eyes and macular edema. She is recently pseudophakic. OD 20/80, OS 20/200.
|
|

Optic Nerve (Disc) Drusen - Spectral Domain Optical Coherence Tomography Line Scan870 views34 Year Old woman no headaches normal vision
|
|

Lattice Degeneration870 views
|
|

branch retinal vein occlusion - oct map869 views70 year old woman with 20/80 vision from a branch retinal vein occlusion and macular edema. She has had laser treatment and intravitreal steroids. Her vision with further laser improved to 20/50.
|
|

Focal Laser for diabetic macular edema869 views66 year old female with diabetes for 45 years. VA 20/20 OU. Extrafoveal edema in the left eye treated with light focal laser.
|
|

Punctate Inner Choroidopathy - PIC and Choroidal Neovascular Membrane - Right Eye - Color Fundus Photograph869 views34-year-old woman with a change in vision in the right eye about eight days ago. Her vision was hazy and she saw waviness in the vision. She does have a history of aches and pains and she was diagnosed with Sjogren’s and 2 months ago she had some fevers and some sinus drainage and that went on for about two months. She is a moderate myope. OD 20/25, OS 20/20.
|
|

Conjunctival Vascular Anomaly869 viewsPatient presents a vascular pattern of blood vessels @ 10 o'clock of the superior-temporal quadrant of the right eye. Patient has had flare ups with anterior scleritis in the past which is controlled by Methotrexate. Patient's VA is currently 20/40 with PH 20/30, right eye.
|
|

Proliferative Diabetic Retinopathy869 viewsFundus photography shows severe fibrosis and arterial narrowing. Peripheral laser scars in both eyes. VA is 20/40, right eye and 20/50, left eye.
|
|

868 views
|
|

Proliferative Diabetic Retinopathy both Eyes Neovascularization of the Disc868 views63-year-old woman has been diabetic for twenty one years who sees new floaters in the right eye. OD 20/40, OS 20/40.
|
|

Cuticular Drusen (Basal Laminar Drusen) and Bilateral Chronic Subfoveal Fluid (Serous Retinal Detachment) unresponsive to monthly Avastin OCT OS868 views66-year-old man with bilateral subfoveal fluid unresponsive to one year of monthly avastin therapy.
OD 20/160, Pinhole 20/80. OS 20/63, Pinhole 20/50. OCT scan shows subretinal fluid with normal choroidal thickness. Fluorescein angiogram shows cuticular/basal laminar drusen. ICG shows no foci of choriocapillaris leakage.
|
|

Multifocal Choroiditis Old Scars - Also Peripapillary Scar 82 Year Old Woman867 views82-year-old woman with multifocal chorioretinal scars, more in the right than the left eye. OD is 20/40, OS is 20/20.
|
|

OCT Video - Takes a LONG time to load - Enhanced S Cone Syndrome - Goldmann Favre - 867 views55-year-old woman while in college her vision was poor even with glasses and she sought evaluation for that. She was told after she had an electroretinogram at USF 15 years ago, that she had something with her blue cones. She does have poor night vision, but her reading vision is pretty good.
VISUAL ACUITY: OD 20/40, OS 20/40
|
|

Acute Non-arteritic Anterior Ischemic Optic Neuropathy Right Eye - Previous NA-AION left eye 867 views69-year-old man previously lost vision in the left eye from nonarteritic anterior ischemic optic neuropathy in 2006. About a week ago and noticed blurred vision in the inferonasal part of the vision in the right eye.
VISUAL ACUITY: Vision OD is 20/16, OS is 20/40
|
|

Birdshot Chorioretinitis Mild - Asymptomatic866 views59-year-old man has birdshot chorioretinopathy in both eyes. Vision OD 20/25, OS 20/20. IOP: OD 16, OS 14. The right eye has a posterior chamber intraocular lens in good position. There is 1+ posterior capsular opacity. The left eye has 2+ nuclear sclerosis.
EXTENDED OPHTHALMOSCOPY:
OD: Vertical C/D ration is 0.8. There is patchy depigmented lesion in the nasal periphery. The retina is attached with peripheral laser.
OS: Vertical C/D ratio is 0.4. There are peripheral punched out lesions in the periphery
|
|

Anomalous Branch Retinal Artery 866 views59-year-old man OD 20/25, OS 20/25. TORTUOUS RETINAL ARTERY – LEF EYE
(POSSIBLE GROUP 2 WYBURN-MASON SYNDROME
POSSIBLE ACEPHALIC MIGRAINES )
|
|

Birdshot Chorioretinitis Mild - Asymptomatic864 views59-year-old man has birdshot chorioretinopathy in both eyes. Vision OD 20/25, OS 20/20. IOP: OD 16, OS 14. The right eye has a posterior chamber intraocular lens in good position. There is 1+ posterior capsular opacity. The left eye has 2+ nuclear sclerosis.
EXTENDED OPHTHALMOSCOPY:
OD: Vertical C/D ration is 0.8. There is patchy depigmented lesion in the nasal periphery. The retina is attached with peripheral laser.
OS: Vertical C/D ratio is 0.4. There are peripheral punched out lesions in the periphery
|
|

Dense Vitreous Floater (opacity) from Vitreous Separation 864 views71-year-old woman with a lamellar macular hole in the left eye and also a dense vision floater in the left eye. OD 20/30, OS 20/25
|
|

Multifocal Choroiditis and Subretinal Fibrosis - 32 yo Female Montage Initial Visit863 views32-year-old woman vision loss in the right eye associated with macular scarring and multifocal choroiditis in 1999 with new vision loss in left eye: OD 20/400, OS 20/50.
2 months post-rx with posterior subtenons kenalog and intravitreal avastin - va os 20/30 and lesion has retracted and organized. It never subsequently grew over 2 years follow-up
|
|

DUSN - Diffuse Unilateral Subacute Neuroretinitis - Nematode863 views
|
|

Pigmented Peripheral Retinal Degeneration863 views42-year old male comes in for routine eye exam and to follow up on peripheral retinal degeneration in both eyes. VA is 20/20, right eye and 20/25, left eye. Patient is asymptomatic with no visual complaints.
|
|

Central Serous Retinopathy Acute - Indocyanine Green Angiogram - Leakage Choriocapillaris 862 views42-year-old man was seen in the office on October 5, 2011. He had noticed starting in August after a course of antibiotic and steroids, that he developed new spots in his vision in the right eye. He may have had an episode like this sometime in the past. He did take steroids a few years ago and his vision did change at that time, but then returned.
VISUAL ACUITY: OD 20/32, OS 20/32
|
|

Prefoveal Opercula after Aborted Stage 2 Macular Hole - Present for 1 Year - VA 20/20 - OCT862 viewsThis pleasant 61-year-old man had a small Stage 2 macular hole, which spontaneously close 12 months ago. He is still bothered by a pre-foveal opercula. OD 20/20.
|
|

Acute Posterior Multifocal Placoid Pigment Epitheliopathy - APMPPE - Fluorescein Angiogram862 views 25-year-old man with one and half weeks ago he woke up with night chills. Also around that time his joints started hurting him. He also has headaches, although the headache at this point is not severe. His vision has been changing for about the last week and a half. He sees some spots in his vision and they are blurred spots. They are not in the central vision.
VISUAL ACUITY: OD 20/32, OS 20/32
|
|

Retinal Detachment Under Oil with Inferior Retinectomy861 viewsVision 2/200 surgery 1 month ago.
|
|

Stargardt's Disease - Macular Dystrophy - 69 Year Old African American Male - 20/200 both eyes861 views69-year-old man has had vision loss in both eyes starting 20 years ago. He was diagnosed at one point with Stargardt’s macular dystrophy. When I saw him, he had retinal atrophy in each eye.
Vision is 20/200 in each eye
|
|

Sturge-Weber Encephalotigeminal Angiomatosis - Facial Hemangioma and Asymptomatic Ipsilateral Diffuse Choroidal Hemangioma860 views61-year-old man with Sturge-Weber syndrome with a hemangioma on the left side of his face.
VISUAL ACUITY: Vision OD is 20/50, PH 20/30; OS 20/80, PH 20/30. IOP: OD 16, OS 19.
|
|

Non-Arteritic Anterior Ischemic Optic Neuropathy - Peripapillary Choroidal Ischemia860 views68-year-old woman noticed central vision loss in the right eye about a week ago. It is getting a little bit better. OD 20/160, OS 20/25.
|
|

Central Serous Retinopathy Acute - Enhanced Depth Imaging OCT - Thickened Choriod860 views42-year-old man was seen in the office on October 5, 2011. He had noticed starting in August after a course of antibiotic and steroids, that he developed new spots in his vision in the right eye. He may have had an episode like this sometime in the past. He did take steroids a few years ago and his vision did change at that time, but then returned.
VISUAL ACUITY: OD 20/32, OS 20/32
|
|

Cuticular Drusen (Basal Laminar Drusen) and Bilateral Chronic Subfoveal Fluid (Serous Retinal Detachment) unresponsive to monthly Avastin 860 views66-year-old man with bilateral subfoveal fluid unresponsive to one year of monthly avastin therapy.
OD 20/160, Pinhole 20/80. OS 20/63, Pinhole 20/50. OCT scan shows subretinal fluid with normal choroidal thickness. Fluorescein angiogram shows cuticular/basal laminar drusen. ICG shows no foci of choriocapillaris leakage.
|
|

Dense Vitreous Floater (opacity) from Vitreous Separation 859 views71-year-old woman with a lamellar macular hole in the left eye and also a dense vision floater in the left eye. OD 20/30, OS 20/25
|
|

Choroidal Melanoma - Exudative Retinal Detachment 82 Year Old Man B Scan Ultrasound Transverce859 views82-year-old man who had 3 falls 2 weeks ago. After the falls he started checking his vision and noticed there was a veil over the left eye, which he had seen for about two weeks in the superior visual field. OD 20/25, OS 20/40
(patient was medically never well enough for brachytherapy and died 6 months later from heart disease)
|
|

Acute Posterior Multifocal Placoid Pigment Epitheliopathy - APMPPE - Red Free Photo859 views 25-year-old man with one and half weeks ago he woke up with night chills. Also around that time his joints started hurting him. He also has headaches, although the headache at this point is not severe. His vision has been changing for about the last week and a half. He sees some spots in his vision and they are blurred spots. They are not in the central vision.
VISUAL ACUITY: OD 20/32, OS 20/32
|
|

Central Retinal Artery Occlusion with Cilioretinal Sparing - Acute - FA Very Slow Filling CRA859 views 77-year-old man was doing fine until midnight of last night when he noticed sudden severe vision loss in the left eye. VISUAL ACUITY: OD 20/20, OS 2/200.
|
|

Serous Retinal Detachment - Hypertensive Retinopathy - 165/120 - Fluorescein Angiogram859 views48-year-old woman noticed when she was blinking there was a white flash in the left eye starting about a month ago. She sees it temporally. OD 20/16, OS 20/20. There is a serous retinal detachment superotemporal to the optic nerve falling short of the fovea. Her blood pressure 165/120.
|
|

Diabetic Retinopathy859 viewsAnnual diabetic exam. VA 20/30, right eye and 20/50, left eye. Fundus photos shows hemorrhages with cotton wool spots. Exudates are visible around the macula in the right eye. Scattered hemorrhages in the left eye.
|
|

Choroidal Nevus with Drusen859 viewsLow risk choroidal nevus with many overlying drusen
|
|

Diabetic Patient with Macular Edema and Blood Pressure 200/95858 views49-year-old decreasing vision over the last year. OD is 20/80, OS 20/80. blood pressure which was 200/95.
|
|

Stage 2 Macular Hole with 20/70 Vision858 views57-year-old woman blurred central vision in the right eye for about two to three weeks. OD 20/70
|
|

Dense Vitreous Floater (opacity) from Vitreous Separation 858 views71-year-old woman with a lamellar macular hole in the left eye and also a dense vision floater in the left eye. OD 20/30, OS 20/25
|
|

Optic Nerve Pit Retinal Detachment - Macular Detachment - 8 Year Old - 5/200 Vision OS858 views8-year-old child on two school exams that his vision was poor in the left eye and his last normal exam was in preschool.
VISUAL ACUITY: OD 20/30, OS 5/200. OS: Vertical C/D ratio is 0.2. There is a whitening on the temporal edge of the optic nerve consistent with an optic disc pit and there is a serous macular detachment.
|
|

Punctate Inner Choroidopathy - PIC and Choroidal Neovascular Membrane - Right Eye - ICG Angiogram858 views34-year-old woman with a change in vision in the right eye about eight days ago. Her vision was hazy and she saw waviness in the vision. She does have a history of aches and pains and she was diagnosed with Sjogren’s and 2 months ago she had some fevers and some sinus drainage and that went on for about two months. She is a moderate myope. OD 20/25, OS 20/20.
|
|

Central Retinal Vein Occlusion with Macular Edema858 viewsPatient notices decreased vision in the left eye. VA is 20/60, left eye. Fundus and Fluorescence Angiogram shows CRVO in the left eye with scattered hemorrhages throughout the retina.
|
|

Choroidal Nevus in Macula 857 views
|
|

Preretinal Fibrosis - Tractional Retinal Detachment - Proliferative Diabetic Retinopathy 857 views33-year-old woman has proliferative diabetic retinopathy in the left eye with fibrosis and tractional retinal detachment. Her vision is hazy in that eye. VISUAL ACUITY: Vision OD is 20/30, OS 20/120
|
|

Central Arterial Occlusion with Embolism Present857 viewsPatient comes in with CRAO in the right eye. VA was hand motion. Fundus photo shows white veil over the retina with 2-emboli in a branch artery temporal in the right eye. She will be evaluated for emboli and followed up in a month
|
|

Drusen Maculopathy - Confluent Subfoveal Soft Hydrophobic Drusen - AMD OU Red Free Image shows Confluent Drusen 856 views73-year-old woman. She is diabetic for thirteen years. She is also on Coumadin for her heart disease.
VISUAL ACUITY: OD 20/25, OS 20/50.
|
|

Fresh Macular Fold following Macula On Superior Retinal Detachment Repair856 viewsMacular fold after pneumatic retinopexy for macula on superior retinal detachment. Visual acuity is 20/200
|
|

Retinal Detachment Secondary to Irregular Retinal Tear856 viewsRetinal Detachment with Irregular Retinal Tear
|
|

Corneal Abrasion with Foreign Body Present 856 viewsER patient comes in with corneal abrasion in the left eye which was getting worst. VA 20/25. Slit lamp exam showed corneal abrasion superiorly at 2-o'clock. Flipped eyelid and foreign body appeared on the upper tarsal plate. Foreign body was removed.
|
|

Gyrate Atrophy - 15 year old male - 20/25 vision both eyes - Positive Family History855 views15 year old male was diagnosed with “retinitis pigmentosa†at age seven. The patient reports that his night vision is poor. He reports he does not notice a visual field change. He reports that his maternal grandfather has lost vision and a cousin has lost vision as well. He reports he has an uncle with some visual changes.
The most significantly affected relative is a 26-year-old legally blind cousin.
20/25+ OD, 20/25 OS.
|
|

Central Retinal Vein Occlusion and Laser Induced Chorioretinal Anastomosis855 views84-year-old woman has age-related macular degeneration in both eyes with foveal atrophy. She also has a central retinal vein occlusion
in the left eye for which she had intravitreal Kenalog and finally chorioretinal anastomosis laser a year
ago. VISUAL ACUITY: Vision OD is 20/160, OS is 7/200
|
|

Treated Melanoma855 viewsTreated melanoma in the right eye. VA is light perception in the right eye.
|
|

X-Linked Juvenille Retinoschisis 10 Year Old Child treated with Trusopt854 views10-year-old child has x-linked juvenile retinoschisis VA 20/60, OS is 20/100. Macula and Vision improved with Trusopt drops.
|
|

854 views
|
|

Proliferative Sickle Retinopathy - Hemoglobin SC854 views53-year-old woman with a new spider-like floater in the right eye for about six days. She sees one big floater and another little one. She does have hemoglobin SC hemoglobinopathy. VISUAL ACUITY: Vision OD is 20/20; OS is 20/50, PH is 20/20.
|
|

Post Lasik Epithelial Ingrowth854 views58-year-old man had a vitrectomy for a macular pucker in the right eye almost two years ago. His vision was good after his cornea surgeon removed the cells from his flap but then recently the cells have regrown and his vision has declined again.
OD is 20/100.
|
|

Cuticular Drusen (Basal Laminar Drusen) and Bilateral Chronic Subfoveal Fluid (Serous Retinal Detachment) unresponsive to monthly Avastin OCT OD854 views66-year-old man with bilateral subfoveal fluid unresponsive to one year of monthly avastin therapy.
OD 20/160, Pinhole 20/80. OS 20/63, Pinhole 20/50. OCT scan shows subretinal fluid with normal choroidal thickness. Fluorescein angiogram shows cuticular/basal laminar drusen. ICG shows no foci of choriocapillaris leakage.
|
|

Sclopteria Chorioretinitis - 16 Year Old Girl - Pellet Injury853 views
|
|

Acute Macular Neuroretinopathy - (AMN) - Spot in Vision OS - 40 Year old Female853 viewsSD OCT shows disruption of the outer retina nasal to the fovea
|
|

Acute Zonal Occult Outer Retinopathy with Severe Peripheral Vision Loss Left Eye 852 views 58-year-old man developed a peripheral vision problem about 25 years ago. OD 20/30, OS 20/40.
|
|

Papilledema - Spectral Domain OCT used for Diagnosis - 14 year old Child852 views14-year-old was with optic nerve swelling asymptomatic - picked up during routine eye exam. OD 20/20, OS 20/32
SD-OCT is used to differentiate optic disc edema from optic nerve head drusen (which are not yet calcified in children).
|
|

Reticular Macular Disease (Pseudo-drusen) Both Eyes - Wet AMD OS - Dry AMD OD FAF851 views84-year-old woman has wet age-related macular degeneration in the left eye and dry macular degeneration in the right eye. She takes the eye vitamins and her vision is stable since she was treated three months ago with Avastin. OD 20/50, OS 20/32
|
|

Acute Posterior Multifocal Placoid Pigment Epitheliopathy - APMPPE - Fluorescein Angiogram851 views 25-year-old man with one and half weeks ago he woke up with night chills. Also around that time his joints started hurting him. He also has headaches, although the headache at this point is not severe. His vision has been changing for about the last week and a half. He sees some spots in his vision and they are blurred spots. They are not in the central vision.
VISUAL ACUITY: OD 20/32, OS 20/32
|
|
| 17965 files on 180 page(s) |
 |
 |
 |
 |
 |
12 |  |
 |
 |
 |
|